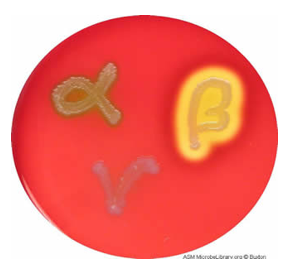

What are the common bacteriology diagnostic techniques? (x4)
□ CULTURE (agar plates): either from sterile sites such as blood and CSF, or non-sterile sites such as skin where commensal bacteria are found. This is the most common! □ SEROLOGY: study of the blood serum to identify body response to infection – antibody testing. □ MOLECULAR TECHNIQUES: such as PCR, electrophoresis, arrays, blotting. □ ANTIMICROBIAL SUSCEPTIBILITY TESTING: phenotypic (meaning can be studied physically in front of you; does not involve studying genes) method of testing susceptibility of bacteria to certain treatments e.g. antibiotic sensitivity using antibiotic discs.
Why do we continue to investigate bacteria in culture?
Seems like a primitive method, but growing bacteria in culture is really good for investigating the effect of drugs/stimuli on the bacteria – ANTIMICROBIAL SUSCEPTIBILITY TESTING. In many cases, we don’t just want to know what bacterial infection a patient has got, but also how to treat it. Culturing bacteria means that we can investigate whether to use an antibiotic or approach treatment differently because of resistance.
Why are molecular techniques not often used in bacteriology?
Molecular methods tell us what bacteria the sample is. This is not what we are most interested in – we are more interested in how we can treat the infection: With a specific antibiotic or a general antibiotic because the infection has resistance? In molecular techniques, in order to know whether a bacterium is antibiotic resistant, you would need to be able to identify SNPs in the genome that give the bacteria the resistance. However, there are 1000s of genes involved in resistance, so this method is too inefficient/unreliable right now. Phenotypic methods such as culturing the bacteria and applying antibiotics to test sensitivity is most efficient.
What is the definition of sterile?
Free from bacteria or other living microorganisms.
What is the first step for blood samples sent to a bacteriology lab?
□ Blood cultures placed in bottles with growth medium. □ One bottle promotes aerobic respiration, whereas the other forces anaerobic respiration. □ Broth inside contains nutrients for bacteria and sample is intubated at 37 degrees. □ Broth and sample are agitated to ensure broth circulates round all the sample. □ Bottom of the bottle contains an indicator. As the bacteria grow, they create toxic metabolites which interact with the indicator which changes colour. □ Machine will flag colour changes as an indicator that bacteria are present. Remember, blood is a sterile medium so shouldn’t have bacteria. □ Usually takes between 16-20 hours.
What happens to blood cultures that are tested positive for bacteria?
□ Bacteria is identified and a diagnosis is made. The first step in identification is GRAM STAINING – determines whether the bacteria is Gram positive or Gram negative. □ Shape and arrangement of bacteria is studied under a microscope. □ More specific tests are carried out after these initial tests to identify the specific bacteria in the blood sample. □ Blood cultures are sent for antimicrobial sensitivity testing on agar plates.
What are the key differences between Gram positive and Gram negative bacteria?
Their cell walls differ! Gram positive bacteria have a thick peptidoglycan cell wall and a single cytoplasmic membrane. Gram negative bacteria have a thin peptidoglycan layer and a lipopolysaccharide outer layer as their cell wall.

How do Gram positive and Gram negative bacteria stain?
□ Gram positive stains deep purple – complex of crystal violet and iodine get stuck in the thick peptidoglycan wall. □ Gram negative do not stain with the primary stain. They are stained pink/red by a counterstain, commonly safranin.
Why is it important to differentiate the Gram staining of bacteria?
Antibiotic treatment differs between the two.
What are the two main groups of Gram positive bacteria? How can these be identified based on shape and arrangement?
□ STAPHYLOCOCCI are spherical (cocci) and divide, forming bunches like grapes.
□ STREPTOCOCCI are spherical (cocci) and divide end on end to form chains.

How are staphylococci bacteria further investigated in a bacteriology lab? What is the significance of coagulase?
□ Staphylococci are split into two groups using a coagulase test which tests the ability of the bacteria to form a clot in plasma. □ They are coagulase positive if they can clot, and coagulase negative if they cannot. □ Coagulase tells us about the pathogenicity/virulence of the staphylococci. Presence of coagulase increases the power of the bacteria to infect.
What are coagulase positive and negative staphylococci?
□ Staphylococcus aureus (including MRSA) is coagulase positive. □ Coagulase Negative Staphylococci are skin commensals of low pathogenic potential. Their presence is usually caused by mixing of skin commensals with blood in venepuncture.
When can coagulase negative staphylococci become problematic?
Can infect prosthetic material (e.g. hip replacements) causing line, pacemaker infections and endocarditis.
How are streptococci further investigated in a bacteriology lab?
□ Bacteria are cultured on blood agar plates – agar plates which contain blood as the medium (usually from a sheep or horse).
□ Streptococci can be distinguished depending on whether they perform alpha, beta or gamma haemolysis.
□ Alpha: incomplete haemolysis i.e. turns agar green. Includes Strep. Pneumoniae (cause of pneumonia and meningitis).
□ Beta: complete haemolysis i.e. clears the agar. Includes Strep. Pyogenes (skin and soft tissue infection) and Strep. Agalactiae (neonatal sepsis).
What, in clinical practice, can pose a challenge to culturing bacteria in a bacteriology lab?
If a clinician suspects a patient has a bacterial infection and administers antibiotics before a blood sample is taken, once blood is taken and sent to bacteriology, the laboratory could underestimate the infection present in the patient when it is tested.
In blood samples, any bacteria found in the sample is flagged. What is studied in non-sterile samples (e.g. faeces) and when are these samples flagged? !!!
□ Bacteriology lab tests for specific bacterium. If any of these specific bacteria are identified in the sample, the lab will flag up results. □ Lab will investigate FOUR bacteria: salmonella, shigella, campylobacter and E coli O157. These are investigated because these are most common. □ Lab also relies on a BEST GUESS FROM CLINICIANS to guide what else they investigate e.g. doctor suspects cholera; so, lab will search for cholera bacterium. □ Depending on patient history, bacteriology lab will also investigate other bacteria e.g. if patient has been in hospital for several weeks and just finished antibiotics, lab will also look for C difficile. Similarly, if patient has been abroad or is immunocompromised, lab will test for parasites. If patient has been admitted from a care home or school with vomiting and diarrhoea, then patient is tested for a virus too.
What methods are used to identify bacteria in stool samples? (x3 points) !!!
□ Bacteria are cultured on agar plates – this is done routinely only for salmonella, shigella and campylobacter. □ In cases of food poisoning, it is not important to know about treatment because antibiotics are never administered. It is more important to identify WHAT the bacteria is. Therefore, stool is investigated with PCR first, and only cultured for susceptibility testing if needed e.g. sample tests positive for Salmonella. □ C difficile is difficult to grow, so culture is not done to identify it. Instead, we use molecular tests – usually toxin detection or PCR for the toxin gene.
What conditions do we want when culturing bacteria from faeces in a lab? Importance of best guess?
□ Faeces contain lots of commensals, so agar medium needs an environment that suppresses commensal bacteria and promotes growth in bacteria we want to identify. For example, agar may contain antibiotics, not all the nutrients needed for growth, or high temperatures e.g. Campylobacter can survive at 42 degrees, so 42 degrees would kill commensals, but allow Campylobacter to thrive. □ Different pathogens have different culture requirements, so a best guess from a clinician is particularly important at tailoring an environment to a bacterium you want to test!
How are parasites tested in faeces? Best guess significance?
Faeces is concentrated, and different stains applied. Again, clinician best guess is needed because different parasites pick up different stains.
What are the different types of agar plate used in bacteriology? Which bacteria do they selectively grow? (x6)
□ Non-selective agar plates: used for blood, as should be sterile apart from bacteria from infection. The rest listed below are SELECTIVE growth media and used to isolate specific bacteria – □ Chocolate agar: H Influenza. □ Macconkey agar: gram negative organisms. □ Blood agar: Streptococci can be distinguished (in previous flashcard). □ Xylose lysine deoxycholate (XLD) agar: Salmonella. □ TCBS agar: Vibrio cholerae.
How is XLD agar selective to Salmonella?
XLD agar: stained red using phenol red. As bacteria grow, they use the sugar xylose in the medium for sugar fermentation – lowering the pH and the phenol red indicator turns yellow. Salmonella ferments the xylose in the same way, but also decarboxylates lysine (found in the medium), increasing the pH and turning the medium back to red again. They also produce hydrogen sulphide, so can be seen on agar as black circles.
How is TCBS agar selective to Vibrio cholerae?
Turns agar green.
What is chocolate agar?
Cooked blood – releases nutrients to allow certain bacteria to grow such as H. Influenza.
How is antimicrobial sensitivity testing carried out? (x2 methods)
□ Minimum Inhibitory Concentrations: The minimum amount of antibiotic required to inhibit growth in vitro. This ‘minimum amount’ is called the breakpoint. The breakpoint is compared to guidelines for an assessment of resistance. If the MIC is LESS THAN 1, the bacteria is sensitive to the antibiotic. If the MIC is MORE THAN 1, the bacteria is considered resistant. □ Measuring zone diameters around antibiotic discs. The wider the disc of clearance around a disc, the greater the effectiveness of the antibiotic.


